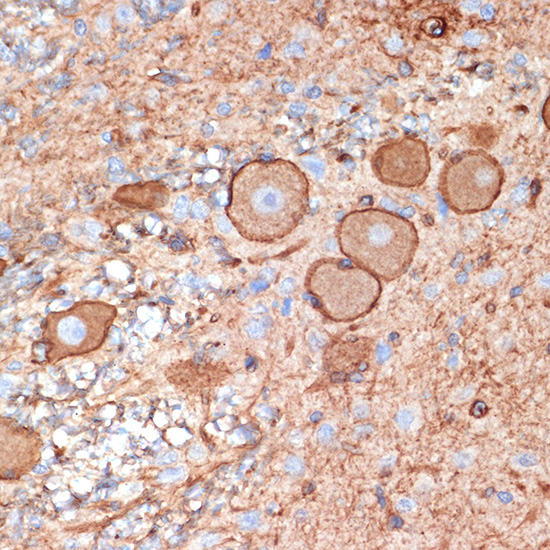

Plectin is a large, widely expressed protein that crosslinks the intermediate filament and actin cytoskeleton, mechanically stabilizing cells and tissues. Plectin also plays a role in the regulation of actin dynamics and acts as a scaffold for signaling molecules. Plectin is important in the stabilization of hemidesmosomes, crosslinking them to the intermediate filament network. Research studies have shown that mutations in plectin and other genes coding for hemidesmosomal proteins can cause epidermolysis bullosa, a condition manifested by fragile skin and frequent blistering . Plectin modulates signals to PKC through binding and sequestration of RACK1, the receptor for activated C kinase 1 . Plectin is also involved in the regulation of cytokeratin architecture and cell stress response , signaling through the chemokine receptor CXCR4 and regulation of AMP-activated protein kinase (AMPK) activity and signaling in mouse myotubes .
| Pack Size | 100ul, 1ml, 20ul |
|---|---|
| Applications | ELISA, IHC-P |
| Host Species | Rabbit |
| Ig Isotype | IgG |
| Antibody Type | Monoclonal Antibody |
| Organism Species | Human |
| Product Synonyms | Plectin |
| Observed Mol Wt | 532kDa |
| Alternative Names | HD1; PCN; EBS1; EBSO; PLTN; EBS5A; EBS5B; EBS5C; EBS5D; EBSMD; EBSND; EBSOG; EBSPA; PLEC1; LGMD2Q; PLEC1b; LGMDR17; Plectin |
| Immunogen (Antigen) | Recombinant protein |
| Format | Liquid |
| Buffer Formulation | 0.05% BSA, 50% glycerol, PBS with 0.05% proclin300, pH7.3 |
| Reactivity | Human, Rat |
| Uniprot ID | 5339 |
| Gene ID | Q15149 |
| Potency (Clone Number) | ARC2270 |
| Purification | Antigen-specific affinity chromatography followed by Protein A affinity chromatography |
| Usage | For Research Use Only. Not for diagnostics or human use. |
| Shelf Life | 12 months at time of shipping |
| Shipping | Shipped in Dry Ice at -20 Degree Celsius |
| Storage | Store at -20 Degree Celsius. It is recommended to aliquot and store to avoid repeated freeze-thaw as it affects the stability of the antibody. |
| Research Areas | Cancer, Cell Biology, Immunology |
| KD/KO Validated | KD Validated |
| Disclaimer | The data indicated herein are as indicated and validated in our laboratory. These reagents are for research use only and not for in-vitro diagnostics or human use. |
![EGFR Rabbit PolyMonoclonal Antibody [KD Validated]](https://www.kinesisdx.com/wp-content/uploads/2025/05/A24388_ARC61438-01_ARC60682-01_KO-WB_01-370x444.jpg)
![KMT5A/SETD8 Rabbit Monoclonal Antibody [KD Validated]](https://www.kinesisdx.com/wp-content/uploads/2025/05/A4136_ARC0916_WB_01-370x444.jpg)
![CPT1A Rabbit Monoclonal Antibody [KD Validated]](https://www.kinesisdx.com/wp-content/uploads/2025/05/A22450_ARC51170-01_WB_03-370x444.jpg)
![CDX2 Rabbit Monoclonal Antibody [KD Validated]](https://www.kinesisdx.com/wp-content/uploads/2025/05/A19030_ARC0450_WB_01-370x444.jpg)
![COPB2 Rabbit PolyMonoclonal Antibody [KD Validated]](https://www.kinesisdx.com/wp-content/uploads/2025/05/A22646_ARC52625-01_ARC52626-01_WB_01-370x444.jpg)
![MRP4/ABCC4 Rabbit Monoclonal Antibody [KD Validated]](https://www.kinesisdx.com/wp-content/uploads/2025/05/A22601_ARC52223-01_WB_01-370x444.jpg)
Reviews
There are no reviews yet.